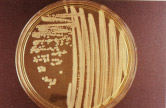
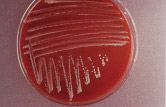

Бруцеллез
Бруцеллез – хроническая инфекционная болезнь, у животных протекает
в скрытой форме, происходят массовые
аборты, заражение последа, метриты и др.
Классификация возбудителя:
Род: Brucella
Виды:
Br. melitensis (овец и коз)
Br. abortus (крупного рогатого скота)
Br. suis (свиней)
Br. canis (инфекционного эпидидимита баранов)
Восприимчивы многие виды сельскохозяйственных и диких животных, включая человека.
Патогенез и факторы вирулентности:
- возбудитель в организм проникает алиментарным и половыми путями;
-
бруцеллы вначале размножаются в ближайших лимфатических
узлах, далее проникают во внутренние органы, инфекция принимает генерализованный
характер. Наиболее благоприятную среду для размножения бруцеллы находят
в беременной матке, что приводит к эндометриту, нарушению питания плода
и аборту;
- факторами вирулентности у бруцелл являются эндотоксины и ферменты патогенности
– гиалуронидаза, каталаза, уреаза.
Методы диагностики:
- материал для исследования: абортированный плод с оболочками, желудок, печень,
почки плода, молоко и др.
- Микроскопия:
- методы окраски: по Граму, по Козловскому;
- микрокартина: мелкие коккобактерии (0,3-0,6мкм ) или мелкие палочки (0,6-2,5
мкм),
располагаются одиночно, парами и небольшими группами);
- грамотрицательные;
- спор не образуют;
- капсулу не образуют;
- неподвижные.
- Культивирование:
-
посев на питательные среды – мясо-пептонный печеночный
бульон (МППБ), мясо-пептонный печеночно-глюкозо-глицериновый агар (МППГГА),
печеночно-глюкозо-
глицериновый
бульон и агар (МГГБ и МГГА) с 10%-ной глюкозой и 2-3% - ным глицерином.
- особенности выделения возбудителя:
- микроаэрофилы;
- выращивают в атмосфере 10-15% СО2 (Br.bovis, Br.ovis в первой генерации);
- остальные виды бруцелл – аэробы;
- оптимальная температура 37oС;
- срок культивирования от 15 до 30 дн.
- культуральные свойства:
- На жидких средах – равномерное помутнение, пристеночное кольцо, незначительный
осадок;
- На плотных средах – мелкие, прозрачные с ровным краем колонии.
- биохимические свойства:
- сахаролитические свойства выражены слабо;
- протеолитические свойства – молоко не свертывают, желатин не разжижают,
сероводород образуют Br. suis в меньшей степени Br. abortus.
- Биопроба: заражают подкожно морских свинок, белых мышей.
Схема лабораторной диагностики бруцеллеза
